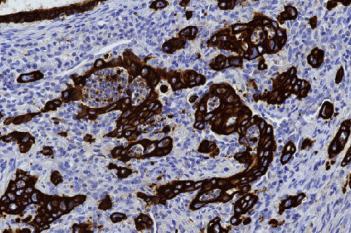
PCK, Tumor Budding, Colorectal Cancer

News
Our promise
We ensure the quality you need to stay ahead
Our unique software combines 20 years of knowledge gained by working with pathologists and research scientists with the power of AI. We provide you with the accuracy and versatility you need to meet the tissue analysis challenges of tomorrow in research and diagnostics. Whether you’re developing next-generation therapies or matching these therapies with the right patients, we ensure the quality you need to stay ahead.
Spatial Biology Analysis
Phenoplex™ is our complete image analysis workflow for all your multiplexed image analysis needs in spatial biology.
Diagnostic decision support
Discover our IVDR certified CE-IVD APPs and our integration workflows that revolutionize standardization through AI-driven pathology solutions.

IHC staining consistency
Measure and document your staining consistency through standardized analysis of next generation reference materials with Qualitopix.